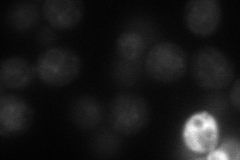
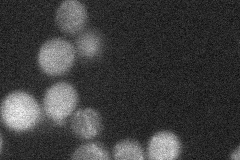
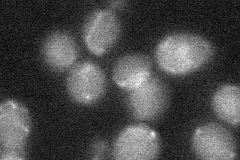
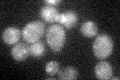
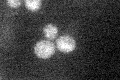

View description
Protein that induces appearance of [PIN+] prion when overproduced; predicted to be palmitoylated
Localization:
Intensity:
Fold change:
Significance:
-
C’ GFP library in SD

punctate,cell periphery31.58 -
N' NOP1pr-GFP in SD
vacuole membrane48.8778 -
N' TEF2pr-mCherry in SD

vacuole44.0364 -
N' NATIVEpr-GFP in SD
ambiguous,punctate20.6739 -
N' TEF2pr-VC and Cyto-VN in SD
below threshold23.4089 -
C’ GFP library in SD+DTT

punctate,cell periphery31.651No -
C’ GFP library in SD+H2O2
punctate,cell periphery30.250.95No -
C’ GFP library in Starvation Media
punctate,cell periphery27.140.85No -
C’ GFP library on the background of Pup2-DaMP

N/A -
C’ GFP library on the background of CCT mutant

N/A0N/AYes
